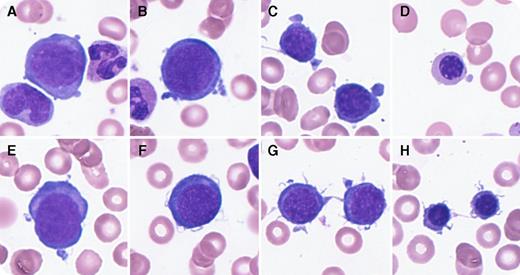
An 18-month-old girl was admitted for anemia and pallor. On admission, laboratory findings included a low hemoglobin (38 g/L), normocytic normochromic anemia pattern (mean corpuscular volume, 81.1 fL), low reticulocyte count (1.4 × 109/L), and elevated erythropoietin (6540 mIU/mL). White blood count and platelet counts were normal, with no findings suggestive of bleeding or hemolytic anemia (lactate dehydrogenase, 220 IU/L; unconjugated bilirubin, 0.3 mg/dL; haptoglobin, 93 mg/dL; and negative for direct antiglobulin test). Bone marrow (BM) examination revealed erythroblastopenia (myeloid/erythroid ratio, 8.5:1). Furthermore, most erythroblasts at various differentiation stages showed deformations, including pseudopodia (panels A-D; 38.1%), filamentous changes on cell surfaces (panels E-H; 33.3%), or both combined abnormalities (19.0%, each frequency in erythroblasts) without any giant erythroblast. Although she had no symptoms, peripheral blood and BM samples were positive for human herpesvirus–6 (HHV-6) (negative for HHV-7, cytomegalovirus, Epstein-Barr virus, and parvovirus) by polymerase chain reaction. After the second blood transfusion, her anemia resolved without recurrence, accompanied with the disappearance of HHV-6. The final diagnosis was transient erythroblastopenia of childhood (TEC). / Few studies have reported HHV-6 as a cause of TEC. In vitro analysis reported that HHV-6 suppressed erythroid-committed progenitor cells and multipotential hematopoietic colonies. However, there was little information about morphologic abnormalities in erythroblasts in TEC caused by HHV-6. These findings show distinct erythroblast deformation in the context of TEC caused by HHV-6.

An 18-month-old girl was admitted for anemia and pallor. On admission, laboratory findings included a low hemoglobin (38 g/L), normocytic normochromic anemia pattern (mean corpuscular volume, 81.1 fL), low reticulocyte count (1.4 × 109/L), and elevated erythropoietin (6540 mIU/mL). White blood count and platelet counts were normal, with no findings suggestive of bleeding or hemolytic anemia (lactate dehydrogenase, 220 IU/L; unconjugated bilirubin, 0.3 mg/dL; haptoglobin, 93 mg/dL; and negative for direct antiglobulin test). Bone marrow (BM) examination revealed erythroblastopenia (myeloid/erythroid ratio, 8.5:1). Furthermore, most erythroblasts at various differentiation stages showed deformations, including pseudopodia (panels A-D; 38.1%), filamentous changes on cell surfaces (panels E-H; 33.3%), or both combined abnormalities (19.0%, each frequency in erythroblasts) without any giant erythroblast. Although she had no symptoms, peripheral blood and BM samples were positive for human herpesvirus–6 (HHV-6) (negative for HHV-7, cytomegalovirus, Epstein-Barr virus, and parvovirus) by polymerase chain reaction. After the second blood transfusion, her anemia resolved without recurrence, accompanied with the disappearance of HHV-6. The final diagnosis was transient erythroblastopenia of childhood (TEC).
Few studies have reported HHV-6 as a cause of TEC. In vitro analysis reported that HHV-6 suppressed erythroid-committed progenitor cells and multipotential hematopoietic colonies. However, there was little information about morphologic abnormalities in erythroblasts in TEC caused by HHV-6. These findings show distinct erythroblast deformation in the context of TEC caused by HHV-6.
An 18-month-old girl was admitted for anemia and pallor. On admission, laboratory findings included a low hemoglobin (38 g/L), normocytic normochromic anemia pattern (mean corpuscular volume, 81.1 fL), low reticulocyte count (1.4 × 109/L), and elevated erythropoietin (6540 mIU/mL). White blood count and platelet counts were normal, with no findings suggestive of bleeding or hemolytic anemia (lactate dehydrogenase, 220 IU/L; unconjugated bilirubin, 0.3 mg/dL; haptoglobin, 93 mg/dL; and negative for direct antiglobulin test). Bone marrow (BM) examination revealed erythroblastopenia (myeloid/erythroid ratio, 8.5:1). Furthermore, most erythroblasts at various differentiation stages showed deformations, including pseudopodia (panels A-D; 38.1%), filamentous changes on cell surfaces (panels E-H; 33.3%), or both combined abnormalities (19.0%, each frequency in erythroblasts) without any giant erythroblast. Although she had no symptoms, peripheral blood and BM samples were positive for human herpesvirus–6 (HHV-6) (negative for HHV-7, cytomegalovirus, Epstein-Barr virus, and parvovirus) by polymerase chain reaction. After the second blood transfusion, her anemia resolved without recurrence, accompanied with the disappearance of HHV-6. The final diagnosis was transient erythroblastopenia of childhood (TEC).
Few studies have reported HHV-6 as a cause of TEC. In vitro analysis reported that HHV-6 suppressed erythroid-committed progenitor cells and multipotential hematopoietic colonies. However, there was little information about morphologic abnormalities in erythroblasts in TEC caused by HHV-6. These findings show distinct erythroblast deformation in the context of TEC caused by HHV-6.
For additional images, visit the ASH IMAGE BANK, a reference and teaching tool that is continually updated with new atlas and case study images. For more information visit http://imagebank.hematology.org.